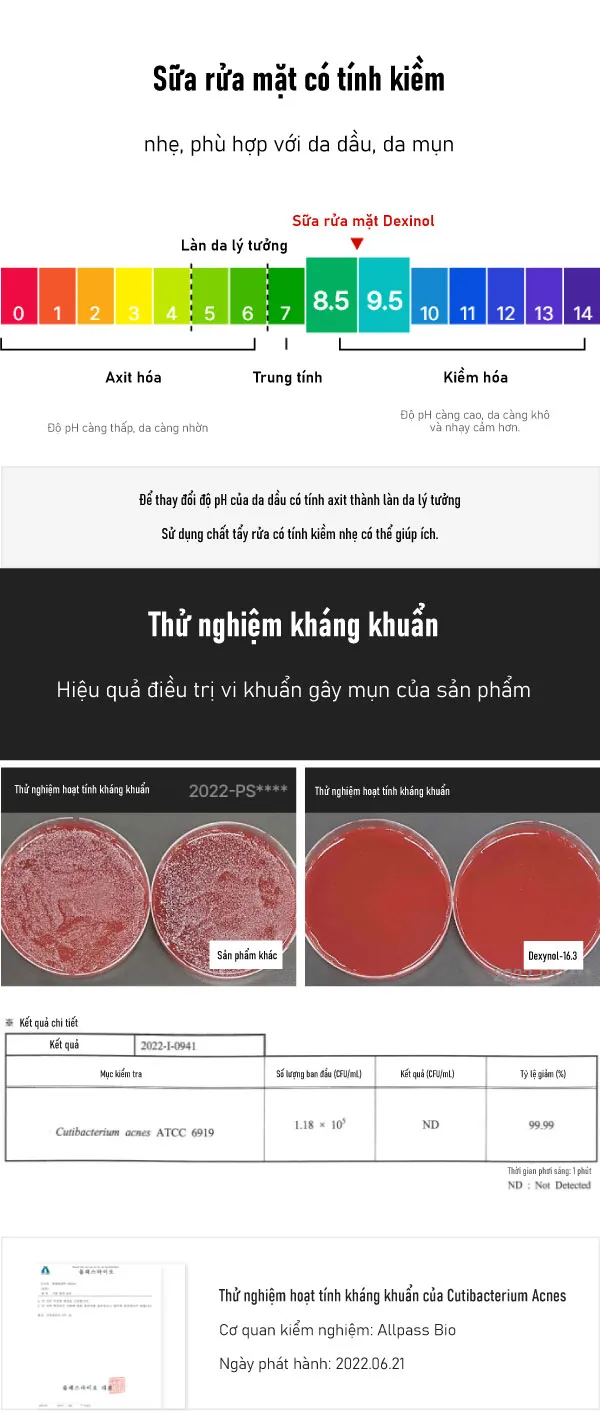

Sữa rửa mặt Dexnol-16.3 Splash Cleanser
350,000đ
– Nhà sản xuất mỹ phẩm và người bán có trách nhiệm :
Kolmar Hàn Quốc / Công ty TNHH Dược phẩm Celtem
– Xuất xứ: Hàn Quốc
– Dung tích: 100ml
THÔNG TIN CHI TIẾT
Miêu tả
Sạch mịn bất ngờ làm sạch bụi bẩn và bã nhờn tích tụ dư thừa trong lỗ chân lông một cách triệt để. Thành phần Micro- Deep Tox TM độc đáo của Precent Science đặc biệt hiệu quả trong việc loại bỏ mụn đầu đen, mụn đầu trắng
Công dụng
- Loại bỏ bã nhờn gây tắc lỗ chân lông
- Làm sạch mụn đầu đen
- Làm sạch mụn đầu trắng...
Thành phần
Nước tinh khiết, axit myristic, glycerin, methylpropanediol, kali hydroxit, coco-glucoside, axit lauric, axit palmitic, axit stearic, axit salicylic, glyceryl stearat, cyanocobalamin, beta-glucan, sorbitan olivate, dinatri EDTA, 1,2-hexanediol, hương liệu
Cách sử dụng
Sau khi tạo lượng bọt vừa đủ, nhẹ nhàng massage lên mặt và rửa sạch bằng nước ấm.

Liên hệ
Sản phẩm liên quan
- Thông báo sửa đổi Chính sách xử lý thông tin cá nhân của Celtem Pharmaceutical
- Về việc phát hiện các đánh giá sai sự thật có ác ý của một đối thủ cạnh tranh bị nghi ngờ
- Thông báo sửa đổi Chính sách xử lý thông tin cá nhân của Celtem Pharmaceutical
- Serum Cellinol-5 chứa thành phần còn vi diệu hơn cả Retinol
